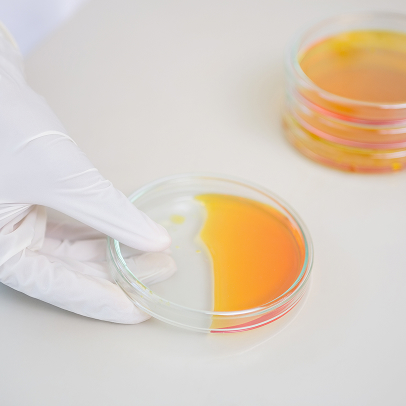
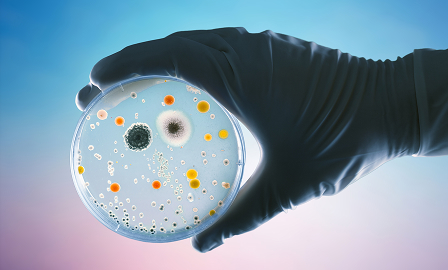
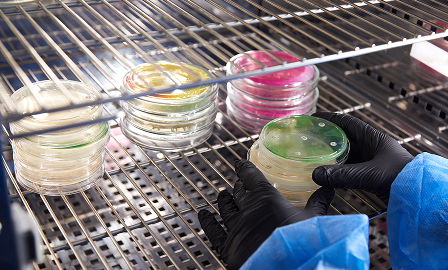

OVERVIEW
Culture media and consumables create the essential environments that allow cells and microorganisms to thrive under laboratory conditions. Whether for research, diagnostics, or production, they provide the nutrients, stability, and reliability needed to generate meaningful, reproducible results.
High-quality media and consumables are more than background materials, they are critical to experimental success. By supporting cell growth and ensuring consistency across workflows, they lay the groundwork for everything from groundbreaking discoveries to life-saving therapies.
PROCESS
Microbial Growth Requirements Defined
Selection of culture media is based on the nutritional and environmental needs of the target microorganism.

Preparation and Quality Control
Media are prepared under controlled conditions, tested for sterility, pH, and performance before use.
Application and Storage
Used in microbial cultivation across labs, media and consumables are stored per guidelines to maintain stability and reliability.

